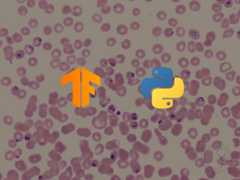
How to Perform Malaria Classification using TensorFlow 2 and Keras in Python

Learn how to build and evaluate predictive models that have the power to help the doctors and transform patient outcomes in Python.

Learn how to build a deep learning malaria detection model to classify cell images to either infected or not infected with Malaria Tensorflow 2 and Keras API in Python.
Learn how to use transfer learning to build a model that is able to classify benign and malignant (melanoma) skin diseases in Python using TensorFlow 2.